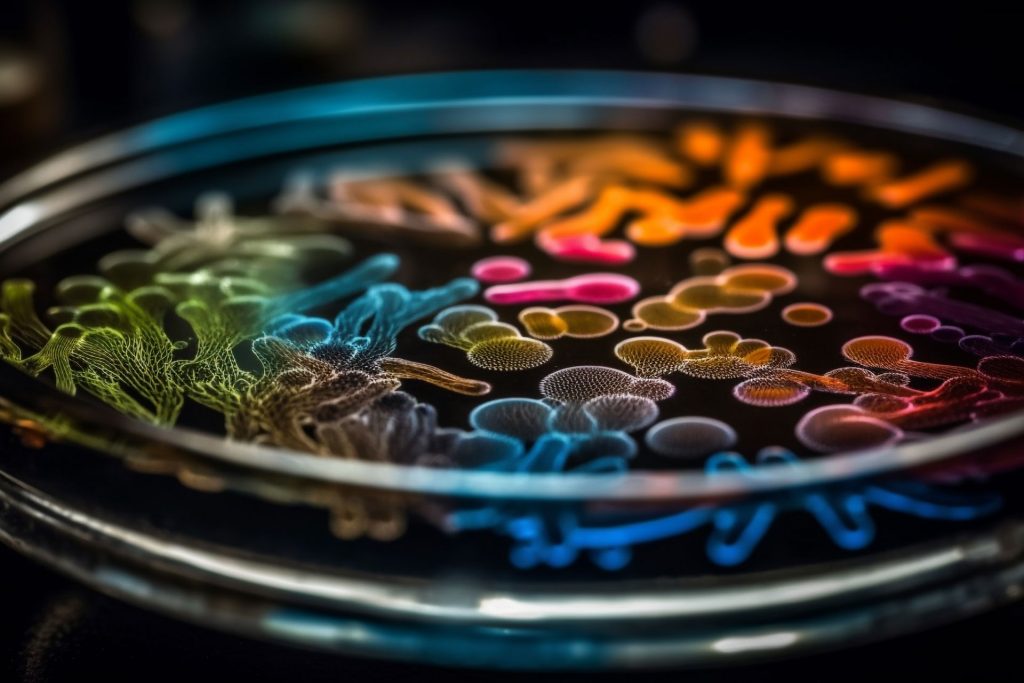

No products in the cart.
Many well-known research companies specialize primarily in marketing, and will sell products suspended in low-grade or undisclosed-grade solvents, or in plastic bottles with disposable external plastic measuring tools that they expect you to use multiple times in research! This causes harmful chemicals to leach into their products during storage and introduces dirt and bacteria into products between testing.
P3 Biologics uses only the cleanest, highest-grade solvent available, 100% USP Grade PEG400 to suspend liquid SARMs, and clean glass bottles with fixed glass measuring droppers to ensure that research products are not tainted by plasticizers, toxins, heavy metals, dirt, or bacteria.